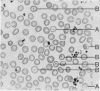

Abstract
A semi-quantitative method of estimating the number of target cells in blood films has been developed. It has been applied to 250 films from normal persons, pregnant women, and patients with a variety of haemoglobinopathies. Allowing for the frequency of target cells found in normal films the results show that such an examination is of value in eliminating or suggesting certain haemoglobinopathies, but not in excluding the majority of the traits.
Full text
PDF

Images in this article
Selected References
These references are in PubMed. This may not be the complete list of references from this article.
- CHERNOFF A. I. The human hemoglobins in health and disease. N Engl J Med. 1955 Sep 8;253(10):416–concl. doi: 10.1056/NEJM195509082531006. [DOI] [PubMed] [Google Scholar]
- CROSBY W. H. The pathogenesis of spherocytes and leptocytes (target cells). Blood. 1952 Feb;7(2):261–274. [PubMed] [Google Scholar]
- DAVIDSON W. M., BAREHAM F. R., KITCHEN L. D., PEGG S. H. An automatic staining machine designed for staining blood films made on coverslips. J Clin Pathol. 1958 Jan;11(1):96–97. doi: 10.1136/jcp.11.1.96. [DOI] [PMC free article] [PubMed] [Google Scholar]
- KAPLAN E., ZUELZER W. W., NEEL J. V. A new inherited abnormality of hemoglobin and its interaction with sickle cell hemoglobin. Blood. 1951 Dec;6(12):1240–1249. [PubMed] [Google Scholar]